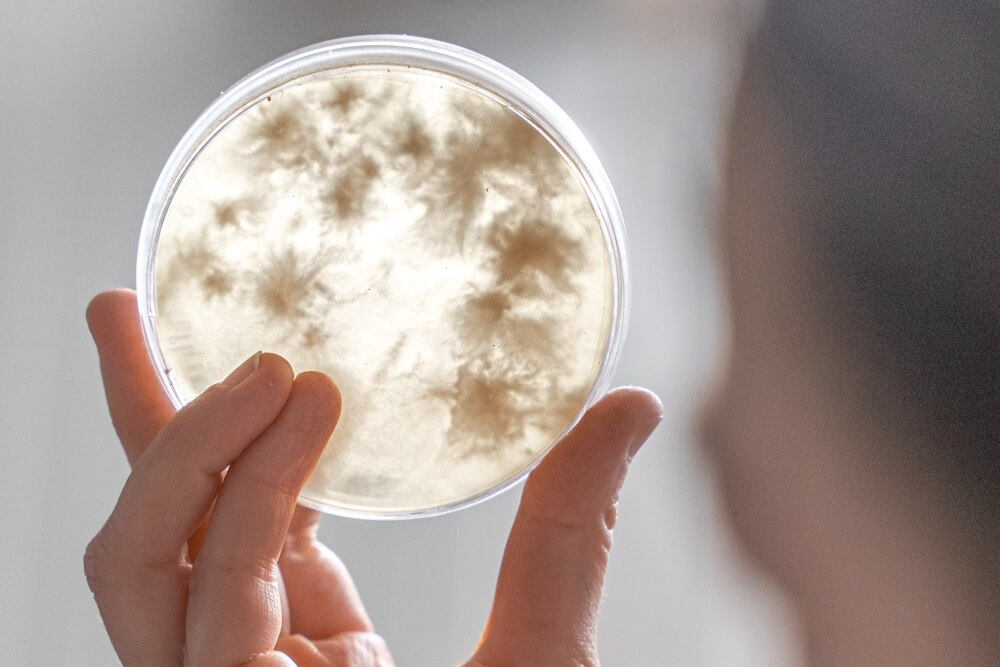

David Šohaj Minařík je jedním z těch vizionářů, kteří o boji proti klimatickým změnám nejen mluví, ale také aktivně jednají. Je zakladatelem společnosti Myco, která mění pravidla hry v obalovém průmyslu, a využívá sílu přírody k výrobě materiálu, který je stejně pevný jako polystyren, ale zcela kompostovatelný. Jak lze zemědělský odpad a mycelium využít k vytvoření plnohodnotné a cenově konkurenceschopné náhrady plastů? Co si David myslí o greenwashingu? A jaký je potenciál žen ve světě startupů?
Mnoho lidí o boji proti klimatickým změnám jen mluví, vy jste se rozhodl jednat. Jaké klíčové momenty nebo motivace vás vedly k založení firmy, jejíž hlavní misí je změnit svět obalových materiálů?
Impulzem byla osobní krize, kdy jsem si uvědomil, že chci dělat něco, co má skutečný dopad. Jako výtvarník jsem s tímto materiálem už předtím pracoval, ale až ve chvíli, kdy se přidal kolega s průmyslovými zkušenostmi, jsme našli cestu, jak z toho postavit reálný byznys a nahradit plasty tam, kde to dává smysl.
Z počátečních experimentů v koupelně jste vybudoval firmu, která láká investory i pozornost médií. Co konkrétně podle vás nejvíce oslovuje? Proč váš nápad získal tak obrovskou podporu?
Že to opravdu funguje a není to jen hezký nápad. Naše obaly chrání stejně dobře jako polystyren, a přitom vznikají z odpadu. Ta jednoduchost a logika toho řešení oslovila jak média, tak investory.
Na jakém základním konceptu Myco stojí a jaký materiál vytváříte?
Bereme zemědělský nebo papírový odpad, naočkujeme ho myceliem houby reishi a necháme prorůst. Vznikne pevný materiál, který pak tvarujeme do obalů či dalších výrobků. Je to stoprocentně přírodní a po použití se to rozloží bez mikroplastů.
PŘEČTĚTE SI TAKÉ: UDRŽITELNOST: 7 TIPŮ, JAK ŠETŘIT PENÍZE I PŘÍRODU

Na mnohé působí svět biotechnologií jako science fiction. Mohl byste laicky popsat proces přeměny organického odpadu a mycelia na pevný materiál? V čem se vaše technologie zásadně liší od jiných inovativních materiálů, které se objevují na trhu?
Odpadní materiál vyčistíme teplem, přidáme mycelium, které funguje jako přírodní lepidlo a celé to proroste. Potom to rozdrtíme, naformujeme, dorosteme, usušíme a máme hotový výrobek. Tvrdý, odolný, a přitom kompostovatelný.
Věříte, že mycelium má obrovský potenciál. Co je na něm jako materiálu tak zvláštního?
Chrání stejně dobře jako polystyren a je cenově konkurenceschopný. Po použití jej stačí hodit na kompost, do bioodpadu. Pokud naše produkty skončí na skládce či ve spalovně, nezpůsobí sekundární zátěž.
Dokázal byste uvést tři překvapivé fakty o houbách?
- Je to největší organismus na světě.
- Geneticky mají houby blíž k lidem než k rostlinám.
- Některé druhy hub dokážou rozkládat ropu nebo toxické odpady.
PŘEČTĚTE SI TAKÉ: KVALITA JDE RUKU V RUCE S UDRŽITELNOSTÍ, I POKUD JDE O POUZDRA NA TELEFON, ALE ČASTO SE NA TO ZAPOMÍNÁ
Jelikož mladší generace žijí rychlým tempem, oceňují praktičnost. Jsou vaše produkty z mycelia stejně odolné a funkční jako tradiční obaly? Jak se o ně starat, pokud je chceme používat opakovaně? A jak je správně likvidovat, když dosáhnou konce své životnosti?
Na jedno použití plně nahradí polystyren. Pokud je použijete víckrát, je dobré je držet v suchu. Po dosloužení se během týdnů až měsíců samy rozloží.
V mnoha firmách je udržitelnost pouze marketingovým nástrojem. Jak vnímáte greenwashing a jak mohou běžní spotřebitelé skutečně ověřit, že firmy, které podporují, berou ochranu životního prostředí vážně?
Greenwashing je bohužel častý, a proto jasně říkáme, že pokud produkt není funkční a cenově konkurenceschopný, nikdy se masově nerozšíří. My nabízíme obojí – kvalitu i cenu – a každý si může ekologické benefity ověřit i doma. Selský rozum by zde, i jinde, měl hrát důležitou roli.
Jak vnímáte postavení žen v dnešním světě startupů a technologií? Jaké vlastnosti jsou podle vás klíčové pro ženy ve vedoucích pozicích, které chtějí uspět v prostředí tradičně dominovaném muži?
Ženy mají výhodu v empatii a schopnosti propojovat lidi. Tyto vlastnosti jsou v byznysu i vědě klíčové a mohou nám pomoci vyzrát na mnoho typů krizí, které současně zažíváme. A proto je velká škoda, že startupové prostředí je pořád spíš mužské.
PŘEČTĚTE SI TAKÉ: VYHNOUT SE PLASTŮM V KAŽDODENNÍM ŽIVOTĚ MŮŽE BÝT JEDNODUŠŠÍ, NEŽ SI MYSLÍTE

Co lze udělat, abychom povzbudili více mladých lidí, zejména žen, k tomu, aby se věnovali kariéře v oblasti vědy, technologií a ekologie?
Ukazovat příklady z praxe. Když vidí, že i z malého nápadu v garáži může vyrůst firma, která mění trh, je to silnější než jakýkoliv slogan. Možná ukázat, že je to sice dřina, ale i velice zajímavé odvětví.
Mycelium se aktuálně používá také ve stavebnictví, módě nebo designu. Která z těchto oblastí má podle vás největší, ale dosud málo prozkoumaný potenciál přinést revoluci?
Velký prostor je v chemickém průmyslu, nábytkářství a módě. Jsou tam obrovské možnosti, které zatím nejsou využité.
Nedávno jste měl příležitost vystoupit na TEDxPragueCountdown 2025: Future of Ecosystems. Co vás nejvíce děsí, když přemýšlíte o budoucnosti naší planety? A co vám naopak dává největší naději?
Děsí mě, že společnost může od klimatických cílů ustoupit. Může je začít ignorovat v nějaké formě rezignace. Naději mi dávají ale opět lidé a fakt, že dnes už máme technologie, které to umí změnit.
Z mého TEDx Talku: „You can keep adding. Keep complicating. Keep rebuilding what already works. Or you can find the one missing piece that changes everything.”
Naděje je existující možnost hledat řešení.
PŘEČTĚTE SI TAKÉ: 5 KAŽDODENNÍCH PRODUKTŮ, KTERÉ OBSAHUJÍ SKRYTÉ PLASTY

Bylo pro vás obtížné zprostředkovat publiku tak složité téma a učinit ho srozumitelným?
Ano, bylo to náročné, protože téma udržitelnosti a nových materiálů je samo o sobě dost složité. Složitost se dá schovat za spoustu dat a grafů, zatímco udělat věc srozumitelnou a jednoduchou je to nejtěžší. Proto jsem šel cestou jasné nosné myšlenky: že skutečná inovace není v komplexitě a složitosti, ale v jednoduchosti, která funguje a každý jí porozumí.
Co si myslíte, že se v našich ekosystémech změní v příštích 10 letech a jakou roli v tom budou hrát inovace?
Budou pod dost velkým tlakem. Inovace v oblasti obnovitelné energie až po nové materiály by měly hodně pomoct. V současné době mnoha stávajících krizí je velice složité prosazovat uplatnění inovativních řešení. Obecně všichni mají rádi, když se toho zas až tak moc nemění. Když je svět přehledný. Ale to si bohužel nyní nemůžeme dovolit.
Za svou práci jste získal řadu ocenění a uznání. Jak se vám daří zůstat nohama pevně na zemi a zachovat si své hodnoty, zatímco usilujete o komerční úspěch?
Vracím se často k tomu, proč jsme toto velké dobrodružství celé začali. Kvůli smyslu, ne kvůli cenám a oceněním.
PŘEČTĚTE SI TAKÉ: „JEDNODUCHEJ A OBYČEJNEJ ZPŮSOB ŽIVOTA MI VYHOVUJE,“ ŘÍKÁ DESIGNÉRKA ANNA MAREŠOVÁ O UDRŽITELNOSTI

S jakými předsudky a mýty se nejčastěji setkáváte v souvislosti s udržitelnými materiály? A jak je vyvracíte?
Klasicky, že jsou dražší a méně funkční. Otázky na kapacitu výroby a v našem specifickém případě nepřiznání deeptech kvality našeho biotechnologického startupu.
Kdybyste mohl mít jen jediný odkaz mladé generaci, která se obává o svou budoucnost, co by to bylo?
Strach má být možná jedním z ukazatelů, ale rozhodně navigátorem. Budoucnost není něco, co se stane samo a čeho nejsme součástí. Budoucnost nyní neexistuje, a i malý krok, každého z nás, se počítá.
Z mého TEDx Talku: „You can keep adding. Keep complicating. Keep rebuilding what already works. Or you can find the one missing piece that changes everything. Complexity is easy. Anyone can add more. Simplicity is hard. It takes taste. It takes focus. It takes saying no to your team, to your ego. Please keep saying this very important no.”
Zdroje: Autorský rozhovor, instagramový profil myco, myco.com, TEDx Talks
$content$